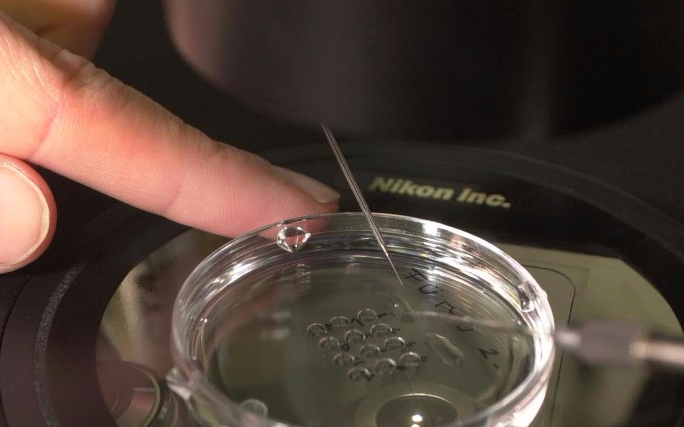
Nem mindig a nő tehet róla

Hírek
2016. Február 24. 09:49, szerda |
Helyi
Forrás: hirado.hu
Nem mindig a nő tehet róla
Általában fel sem merül, hogy a férfi miatt marad el a gyermekáldás, holott a nőknél ma már jóval több a meddő férfi. Minden ötödik pár küzd a gyerekért.
Egyre nagyobb probléma a meddőség Magyarországon, de a közgondolkodással ellentétben nemcsak a nők meddősége okoz problémát babavállaláskor. A férfimeddőség egyre gyakoribb, sőt 2035-re akár kritikus szintre is érhet. Elképzelhető, hogy igen sok férfi az alacsony spermaszám miatt már nem lesz képes gyermeknemzésre – derült ki egy budapesti kerekasztal-beszélgetésen, amelyen professzorok és orvosok vettek részt.
Minden ötödik pár küzd a babáért
A gyermekre vágyó párok közül minden ötödik hosszú küzdelmet folytat a gyermekért. Míg 10-20 évvel ezelőtt a férfiak és nők fele-fele arányban voltak „felelősek” a meddőségért, addig ma már az esetek 60 százalékában a férfiak, s csupán 40 százalékban a nők miatt marad el a gyermekáldás.
A férfiak zöme nem gondolja, hogy ő is lehet meddő
A férfiakban szinte fel sem merül, hogy ők is lehetnek meddők. Általában csak akkor szánják rá magukat, hogy orvoshoz menjenek, amikor a nő már számtalan vizsgálaton átesett és egyértelművé válik, hogy nem nála van probléma.
Ha a férfiak tudomást is szereznek róla, hogy meddők, többnyire elutasítják a felelősségüket, sokszor hárítanak és szégyellik a dolgot. „Holott a terméketlenség nem impotenciát jelent, nem szégyellnivaló dolog" – mondta dr. Szöőr Anna pszichológus.
Drasztikusan csökken a spermiumok száma világszerte
Az első felmérések 1938-ban készültek. Akkor még 120 millió spermium volt 1 ml ondóban. Ez a szám a ’90-es években 70 millióra csökkent, és ha a tendencia ilyen ütemben folytatódik, akkor 2030-ra a 20 milliós érték alá csökkenhet, amely alatt nem következik be a megtermékenyítés. Így elképzelhető az andrológusok és a WHO szerint az, hogy a férfi nem lesz képes megtermékenyíteni a nőt – mondta prof. dr. Ősapay György, a Magyar Tudományos Akadémia nagydoktora.
Megdöbbentő adatok
A magyar népszaporulat egyébként régóta csökkenő tendenciát mutat. Míg a '48-as forradalomnál 10 nőnek még 48 gyereke született, ma már ott tartunk, hogy 10 nőnek csak 13 gyereke születik, tehát a reprodukciós ráta 1,3-1,4 körüli. Ezen érték alatt azt mondják a matematikával foglalkozók, hogy már nehezen lehet visszafordítani a csökkenést – állítja dr. Makay Zsuzsa szociológus.
A KSH Népességtudományi Kutatóintézetének tudományos titkára úgy látja, hogy a magyar fiatalok többsége szeretne családot alapítani és gyermeket nemzeni. Ezért reménykedhetünk abban, hogy a CSOK-program lendíteni fog a gyerekvállalási kedven, a termékenységi arányszámon – tette hozzá a szakember.
A meddőség okai
A meddőség hátterében egyrészt a stressz áll. A hormonrendszer alakulására ugyanis hatással van mind a munkahelyi, mind a családi, mind a környezeti stressz. Felelőssé tehető továbbá az ülő életmód. A spermiumokat tároló herék a sok ülés során egy fokkal melegebben vannak, s a meleg csökkenti az életképességüket. A meddőség oka lehet továbbá az alkohol, a dohányzás, a kávé, az étrendben bekövetkezett negatív változások és a különböző teljesítményfokozók szedése.
A férfimeddőség kezelhető
Pubertás kortól a fiúk spermaszáma folyamatosan csökken, tehát az öregedéssel egyre kevesebb. Ezen változtatni nem lehet, de vannak olyan gyógyhatású készítmények, amelyek képesek növelni a spermiumszámot.
Ezek érdekelhetnek még
2026. Június 19. 08:39, péntek | Helyi
A tulajdonos élőben figyelte a betörést, végül Budapesten fogták el a gyanúsítottakat
A kiskunfélegyházi tulajdonos élőben nézte végig a lopást, azonban a kamerán keresztül ráordított a betörőre, aki elszaladt. Végül a feltételezett elkövetőt és társát budapesti otthonukban fogták el a rendőrök.
2026. Június 12. 11:49, péntek | Helyi
Augusztusban érvényüket vesztik a régi, könyv formátumú személyazonosító igazolványok
2026. Június 12. 11:42, péntek | Helyi
Vasárnap országos vásár Kiskunfélegyházán
Félegyházi Városfenntartó Nonprofit Kft. Piac- és Vásárüzemeltetési részlege tájékoztatja a vásárlókat és az árusokat, hogy a Kiskunfélegyházi Országos Állat és Kirakodó vásár időpontja: 2026. június 14. (vasárnap).
2026. Június 11. 14:12, csütörtök | Helyi
Elektromos rollerek használatának korlátozását kezdeményezi a városvezetés
A tegnapi napon súlyos elektromos rolleres baleset történt a Kossuth Lajos utcán. A sérültnek ezúton is mielőbbi és teljes felépülést kívánok.
